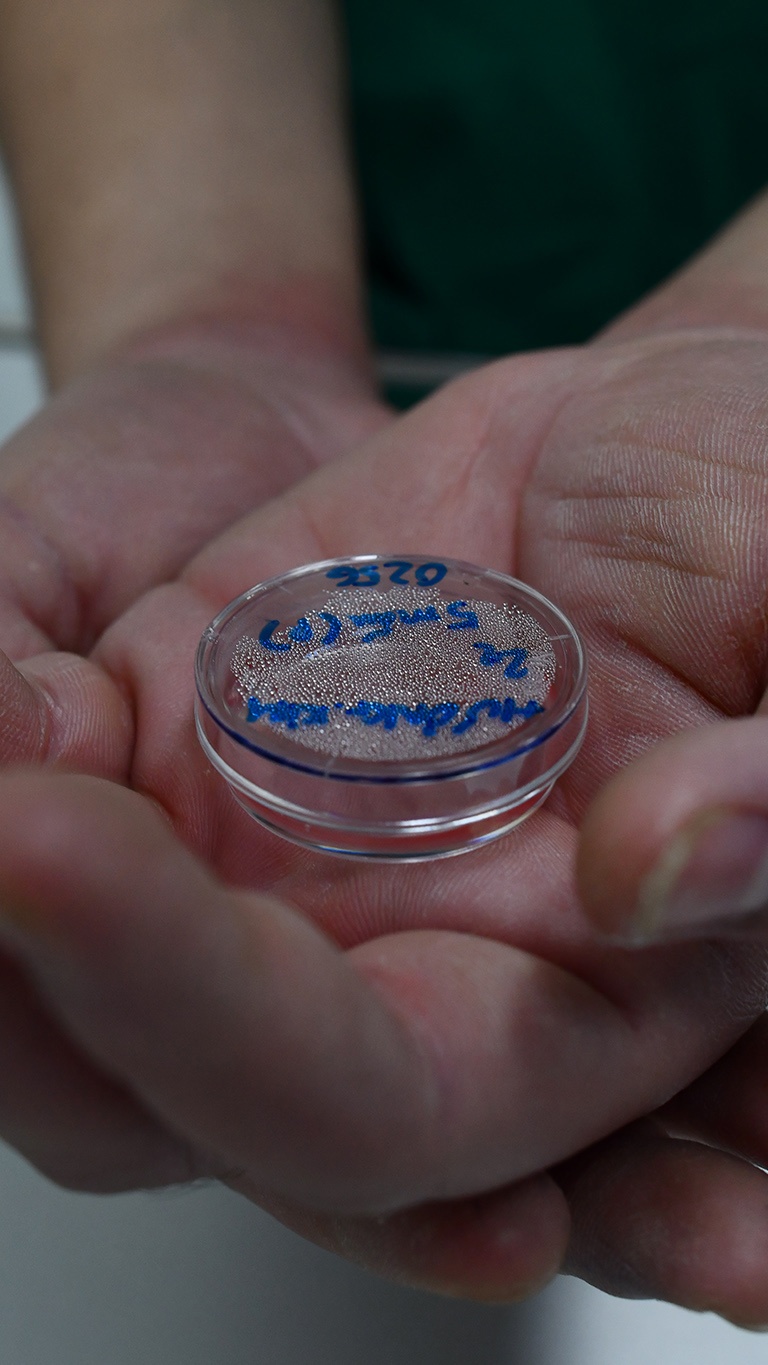
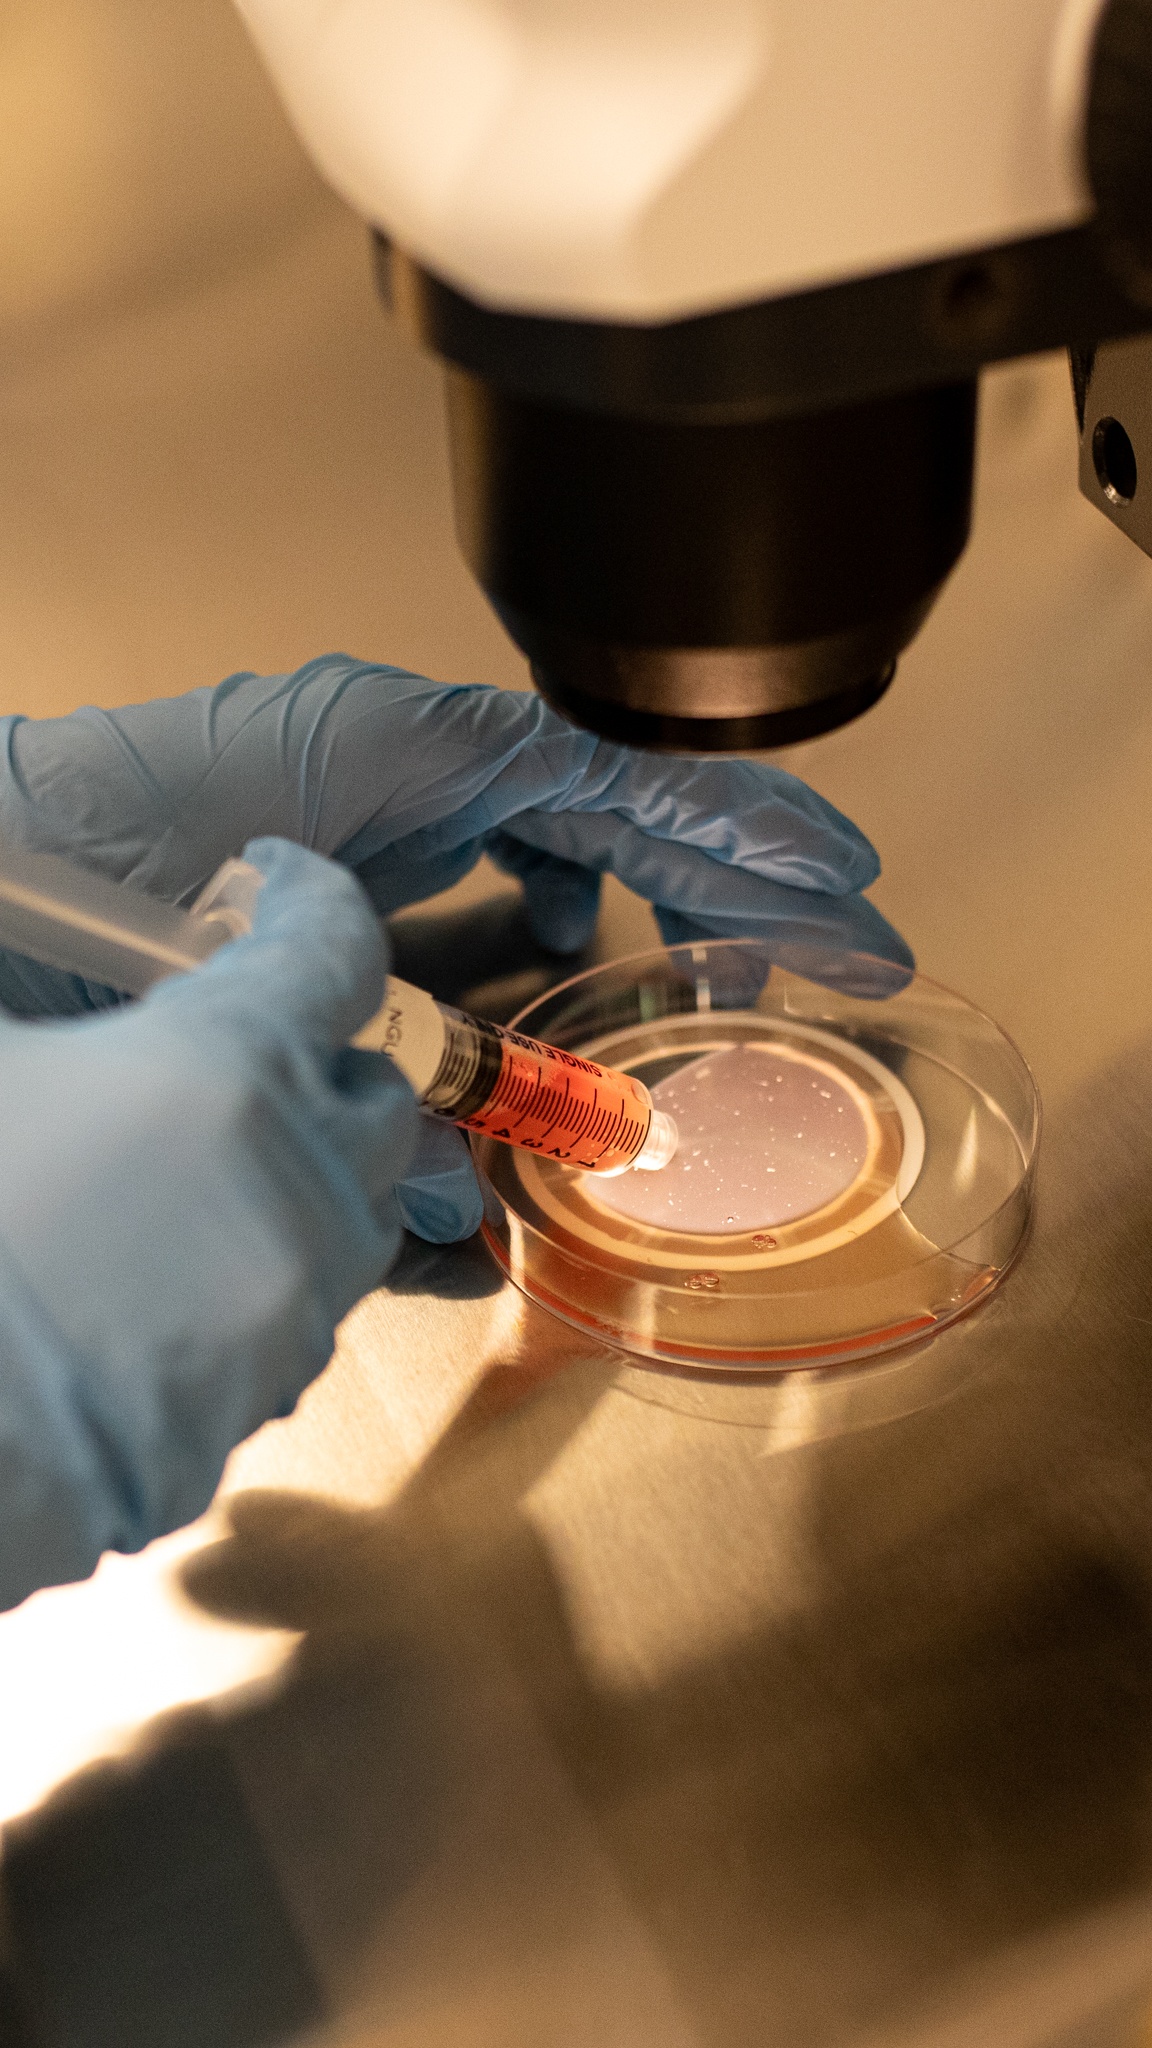
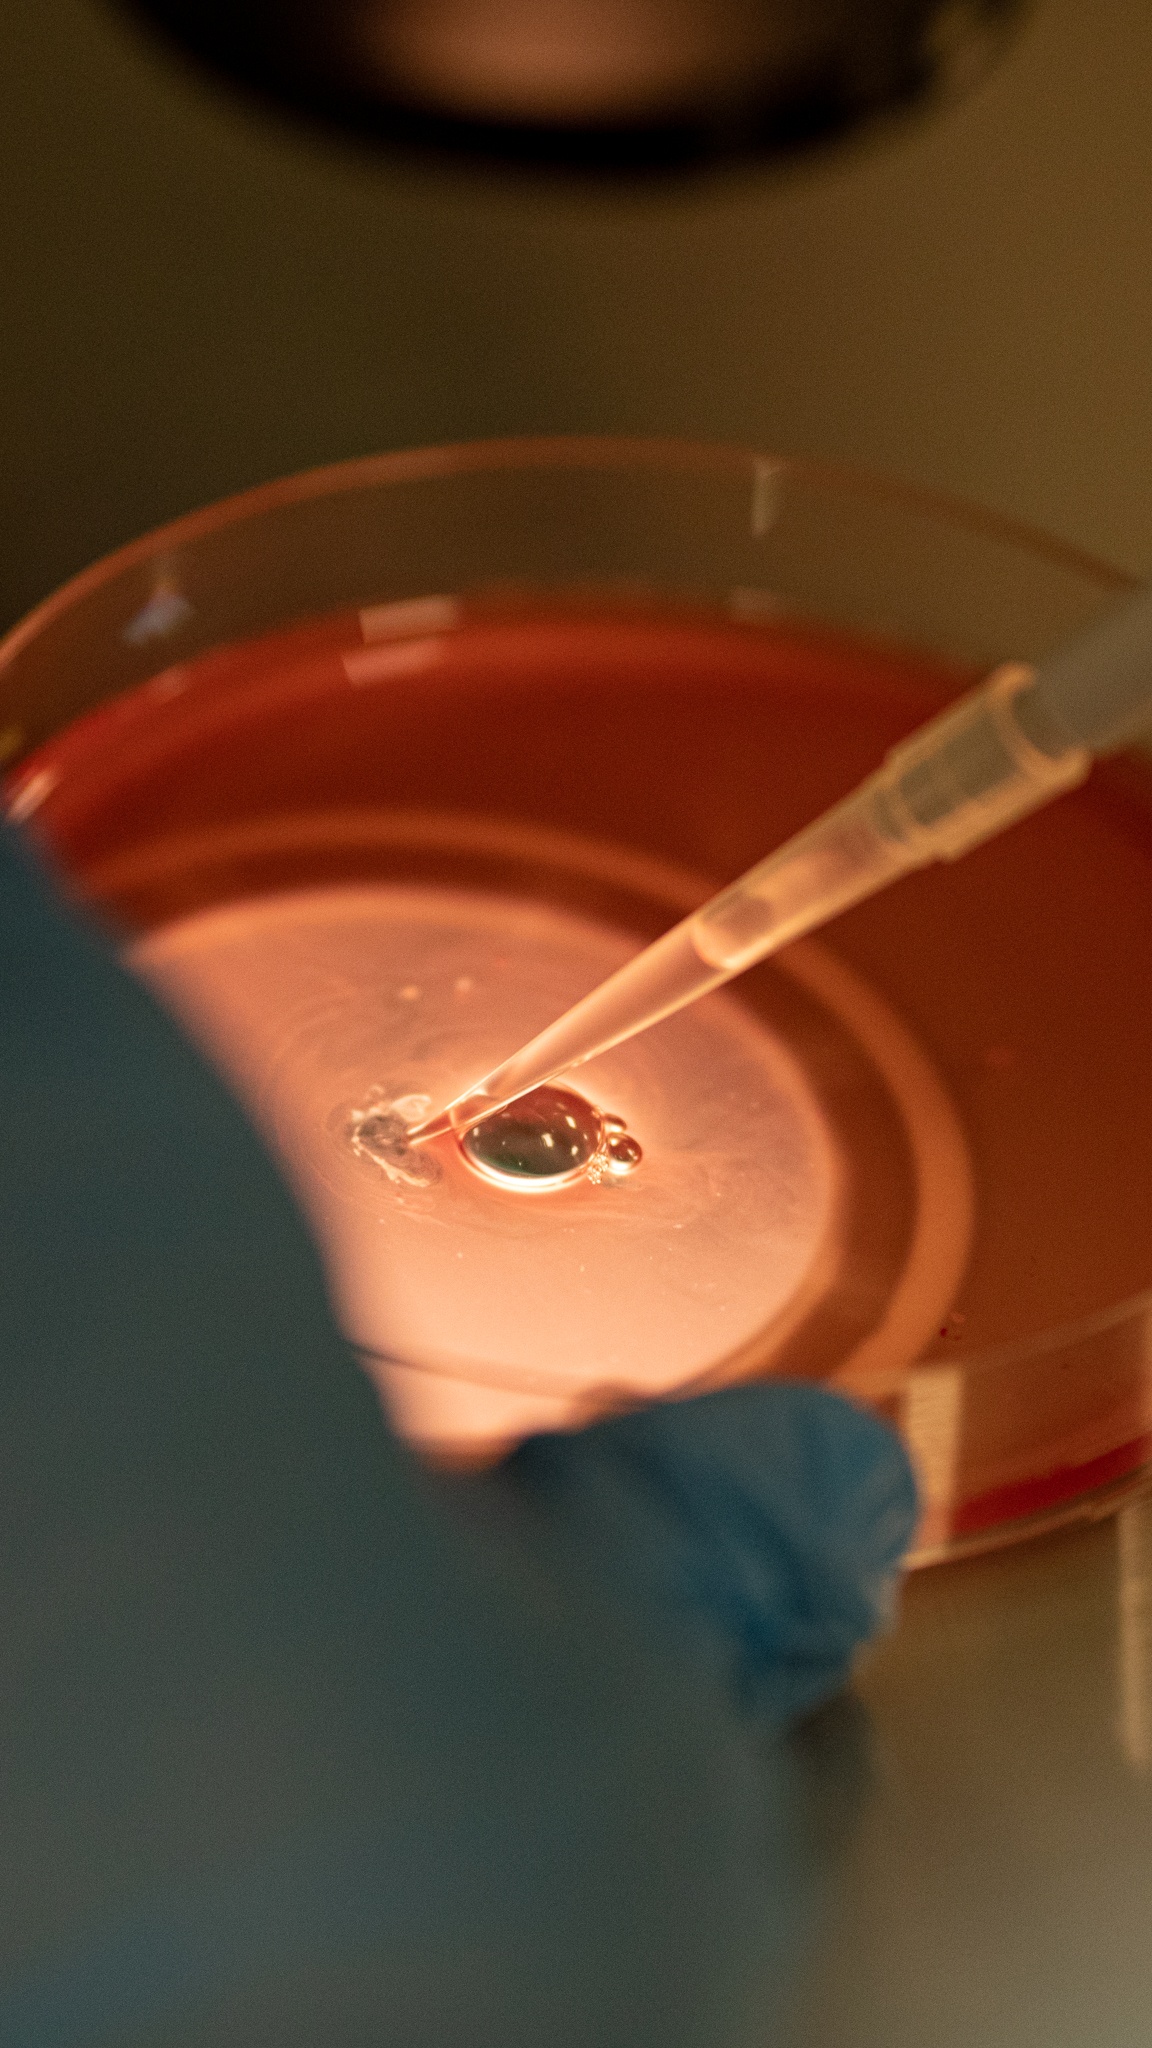

![]() |
| Tôi là ThS.BS Lê Đăng Khoa, Trưởng đơn vị Nam học, Trung tâm Hỗ trợ Sinh sản, Bệnh viện Đa khoa Tâm Anh TP.HCM. Cùng với các đồng nghiệp, tôi luôn nỗ lực để mang lại niềm vui cho những cặp vợ chồng vô sinh hiếm muộn, chắt chiu từng cơ hội dù nhỏ nhất. |
![]() |
| Hôm nay, chúng tôi chuẩn bị phẫu thuật cho một bệnh nhân nam đã 44 tuổi bị vô tinh không bế tắc (NOA) do hiện tượng “sinh tinh giữa chừng". Trước đó, người đàn ông này nhận kết quả mổ sinh thiết tinh hoàn và được kết luận chỉ có thể có con từ nguồn ngân hàng tinh trùng hiến tặng. Tuy nhiên, chúng tôi quyết định ứng dụng kỹ thuật micro-TESE hiện đại. Đây được xem là cứu cánh cho những bệnh nhân “vô tinh" muốn được làm “cha chính chủ”. |
![]() |
| IVFTA HCM là Trung tâm HTSS duy nhất trong nước có thể tiến hành đồng thời vi phẫu micro-TESE tại phòng mổ để lấy mẫu, di chuyển mẫu lên labo để tìm tinh trùng và chọc hút noãn ở phòng thủ thuật sát phòng thí nghiệm (labo), sau đó tiến hành kỹ thuật ICSI (bơm tinh trùng vào bào tương noãn tạo phôi). |
![]() |
| Để quy trình này vận hành trơn tru, chúng tôi “điều động” ê-kíp gồm 2 chuyên viên phôi học trong phòng mổ để tiếp nhận mẫu, 2 chuyên viên phôi học vận chuyển mẫu lên labo ở lầu 7 và 1 nhân sự chỉ đứng giữ thang máy để tối ưu thời gian. Với kỹ thuật này, áp lực về thời gian là rất lớn. |
![]() ![]() |
| Như thường lệ, chúng tôi hoàn thành các bước sát khuẩn, thay trang phục trước khi thực hiện ca mổ. Các thành viên phải thống nhất giao thức của toàn bộ quá trình phẫu thuật. Dù có nhiều năm kinh nghiệm, tôi cùng ê-kíp vẫn phải rất cẩn trọng bởi sự chuẩn bị kỹ lưỡng là yếu tố tiên quyết để mang lại kết quả tốt nhất. |
![]() |
| Cùng lúc này, các điều dưỡng chuyển bệnh nhân vào phòng mổ. Suốt 6 năm qua, sau mỗi lần gõ cửa các trung tâm hỗ trợ sinh sản, người đàn ông này cùng vợ lại nhận thêm những nỗi buồn. Dẫu vậy, họ chưa bao giờ ngừng mong ngóng đứa con đầu lòng. Nhiều năm công tác trong lĩnh vực hỗ trợ sinh sản, tôi rất đồng cảm và thực sự hy vọng giúp được ông và gia đình. |
![]() |
| Trước khi tiến hành phẫu thuật, bệnh nhân được gây tê. Ông sẽ hoàn toàn tỉnh táo và có thể trò chuyện với bác sĩ trong suốt quá trình thực hiện phẫu thuật. Ca mổ lần này dự kiến kéo dài khoảng 90 phút. |
![]() |
| Trong khi đó, một thành viên của ê-kíp sẽ chuẩn bị và sắp xếp bộ dụng cụ vi phẫu. Ca vi phẫu micro-TESE được thực hiện dưới sự dẫn đường của kính hiển vi. Dụng cụ phục vụ ca mổ phải được sản xuất với độ chính xác cao nhằm đảm bảo hiệu quả phẫu thuật tốt nhất. Toàn bộ dụng cụ đều được vô khuẩn nghiêm ngặt và sẵn sàng khi bác sĩ cần. |
![]() |
| Lúc này, tôi cùng một số bác sĩ “mặc áo” cho kính vi phẫu nhằm hạn chế khả năng nhiễm khuẩn do bụi từ kính rơi vào vùng phẫu thuật. IVFTA-HCM đầu tư 7 tỷ cho chiếc kính hiển vi có độ phóng đại 30 lần, đây sẽ là “bạn đồng hành” của tôi trong 90 phút sắp tới. Tôi hay đùa với đồng nghiệp chiếc kính như “con mắt thứ ba của Nhị Lang Thần”, giúp tôi tìm kiếm chính xác những vùng còn khả năng sinh tinh (trùng). |
![]() |
| Phía trên bàn mổ, các thành viên còn lại sắp xếp và khởi động trang thiết bị cùng một số loại máy cần thiết khác trong quá trình phẫu thuật. |
![]() |
| Đúng 8h, các bác sĩ gây mê trò chuyện và thăm dò một số phản ứng của cơ thể người bệnh, trước khi ca phẫu thuật bắt đầu. Việc làm này nhằm trấn an và đảm bảo tình trạng sức khỏe của bệnh nhân tốt nhất. |
![]() |
| 8h08, tôi thực hiện đường rạch da đầu tiên để đưa tinh hoàn của bệnh nhân ra ngoài. Nhiệm vụ của chúng tôi trong 90 phút tới là “truy tìm” các ống sinh tinh từ tinh hoàn bệnh nhân và đảm bảo tổn thương ở mức thấp nhất, qua đó bảo tồn khả năng sinh sản trong tương lai. |
![]() |
| Thời điểm tiếp cận được tinh hoàn của bệnh nhân cũng là lúc chiếc kính vi phẫu phát huy tác dụng. Thông qua hình ảnh được phóng đại đến 30 lần, chúng tôi nhanh chóng phát hiện được các vùng sinh tinh “tiềm năng" và thu thập những đoạn ống sinh tinh đầu tiên. |
![]() |
| Ống sinh tinh ngay lập tức được đưa vào đĩa petri để bảo quản. Bên trong chiếc đĩa này chứa môi trường dinh dưỡng chuyên dụng, đảm bảo giữ tinh trùng tồn tại ở trạng thái lý tưởng nhất. Mỗi chiếc đĩa được ghi chú thông tin cơ bản của bệnh nhân như tên, tuổi, mẫu thu được bên tinh hoàn (phải hay trái), số lượng mẫu thu được... |
![]() |
| Chiếc đĩa được nâng niu trong lòng bàn tay để giữ ấm ống sinh tinh. Chúng tôi vẫn hay gọi đây là “báu vật” của Trung tâm Hỗ trợ sinh sản. Sau khi nghe hiệu lệnh “chuyển mẫu" từ tôi, một nhân viên y tế sẽ đưa đĩa petri này tới labo để tìm tinh trùng cho bệnh nhân. |
![]() |
| Tại phòng thí nghiệm, một chuyên viên đã đứng chờ trước đó, sẵn sàng nhận đĩa petri từ phòng mổ. |
![]() |
| Các chuyên viên sẽ đưa ống sinh tinh trong đĩa petri đến bàn kính để thực hiện thao tác xé mô. Công đoạn này gồm 2 bước là đại thể và vi thể. |
![]() |
| Thông qua kính hiển vi đảo ngược với độ phóng đại lên tới hơn 200 lần, các chuyên viên phôi học và bác sĩ tại phòng mổ có thể nhìn rõ tinh trùng bên trong ống sinh tinh của bệnh nhân. |
![]() |
| Tại phòng mổ, hình ảnh và kết quả tìm tinh trùng từ phòng thí nghiệm được truyền hình trực tiếp (livestream) và thông báo qua iPad. Qua đó, các bác sĩ xác định được lượng tinh trùng cần thiết cho việc thụ thai. Trường hợp chưa đủ sẽ phải lấy thêm. Một số khác thu thập thêm mẫu để dự trữ cho những lần thụ tinh ống nghiệm tiếp theo, giúp bệnh nhân không cần phẫu thuật thêm, giảm chi phí và tình trạng đau đớn không đáng có. |
![]() |
| May mắn, kết quả cho thấy bệnh nhân đã có đủ số lượng mẫu cần thiết cho lần thụ tinh ống nghiệm này cùng 2 mẫu dự trữ cho lần điều trị tiếp theo. Tôi cùng ê-kíp có thể làm sạch và khâu đóng vết mổ. |
![]() |
| Trong suốt ca mổ, tình trạng sức khỏe cũng như các chỉ số sinh hiệu của bệnh nhân đều ổn định. Chúng tôi kiểm tra lần cuối trước khi đưa bệnh nhân về phòng nghỉ. |
![]() |
| Tại phòng thí nghiệm, sau khi xác định được tinh trùng, thạc sĩ Nguyễn Ngọc Quỳnh, Trưởng labo, cùng các kỹ thuật viên thực hiện thao tác xé mô tinh hoàn và lọc rửa tinh trùng. |
![]() |
| Chỉ những tinh trùng trưởng thành, khả năng thụ tinh cao mới có cơ hội "gặp" noãn (trứng). Do đó, lọc rửa, lựa chọn tinh trùng là công đoạn quan trọng nhằm cải thiện tỷ lệ thành công của các kỹ thuật hỗ trợ sinh sản, đặc biệt là trường hợp vô sinh từ yếu tố nam. |
![]() |
| 9h30, sau khi gây tê, ê-kíp của bác sĩ Châu Hoàng Phương Thảo, Phó giám đốc Trung tâm Hỗ trợ sinh sản BVĐK Tâm Anh TP.HCM, bắt đầu chọc hút trứng cho người vợ ở phòng thủ thuật sát cạnh labo. Người vợ chưa từng làm IVF, sức khỏe hoàn toàn bình thường. |
![]() |
| Noãn (trứng) của người vợ sau đó được chuyển tới phòng thí nghiệm cho các kỹ thuật viên xử lý. |
![]() |
| Sau khi đảm bảo đủ noãn và tinh trùng, các kỹ thuật viên bắt đầu thực hiện thụ tinh trong ống nghiệm. Tinh trùng trưởng thành, khỏe sẽ được bơm vào bào tương noãn. |
![]() |
| Công đoạn này phải được thực hiện với sự thận trọng cao. Các kỹ thuật viên cần đặc biệt lưu ý thao tác để tránh thoi vô sắc (Meiotic spindle). Có khoảng 10% tế bào noãn có thể bị tổn thương thoi vô sắc trong quá trình ICSI. Để hạn chế điều này, các nhà phôi học sẽ tiêm tinh trùng vào noãn tại vị trí đặt thể cực 6 giờ hoặc 12 giờ. |
![]() |
| Bằng kính hiển vi quang học sử dụng ánh sáng phân cực, bác sĩ có thể quan sát hình thái thoi vô sắc, từ đó đánh giá sự trưởng thành của noãn trước khi thực hiện ICSI, giúp tiên lượng chất lượng phôi tốt, tăng tỷ lệ IVF thành công. |
![]() |
| Trước khi thực hiện ICSI, chuyên viên phôi học giữ noãn bằng kim chuyên dụng, đồng thời sử dụng hệ thống kính hiển vi phân cực kết hợp camera để quan sát thoi vô sắc và chọn vị trí ICSI phù hợp trước khi tiêm tinh trùng. Đặc điểm noãn và thoi vô sắc sẽ được ghi nhận lại, nhằm hỗ trợ quá trình lựa chọn phôi chuyển cho người bệnh. |
![]() |
| Phôi sau khi thụ tinh được các chuyên viên nuôi cấy, theo dõi sự phát triển với hệ thống máy nuôi phôi hiện đại hàng đầu thế giới, gắn camera quan sát liên tục và ứng dụng AI. Phôi phát triển bình thường sẽ được chuyển vào buồng tử cung để làm tổ và trở thành thai nhi. |
![]() |
| Các mẫu tinh trùng chưa dùng đến được dự trữ và bảo quản lạnh trong thiết bị chuyên dụng có nhiệt độ, môi trường tiêu chuẩn cho đến khi bệnh nhân có nhu cầu sử dụng trong những lần tới. |
![]() |
| Kỹ thuật micro-TESE hay các thao tác trong hỗ trợ sinh sản nói chung luôn đòi hỏi sự tỉ mỉ và cẩn trọng. Từ đây, chúng tôi tự đặt ra những nguyên tắc để đảm bảo có thể giúp các gia đình hiếm muộn sớm có con và bảo tồn khả năng sinh sản của người chồng trong tương lai. Tôi vẫn hay nói với các đồng nghiệp: “Bác sĩ hỗ trợ sinh sản chỉ lo việc nhỏ, không lo chuyện lớn. Nhưng những thứ nhỏ rồi sẽ lớn”. |

Bình luận